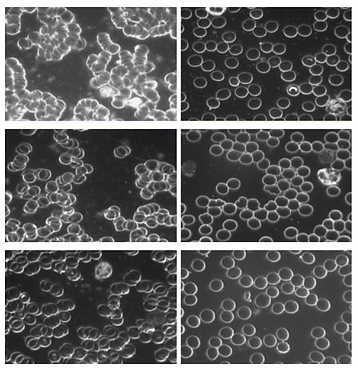
blood.png

New Technologies
New Humanity Foundation’s Research and Development project is an innovative scientific research initiative that aims to establish the effectiveness of high vibrational technology devices in accelerating human consciousness development.
What are Vibrational Healing Technologies?
Vibrational healing technologies are the new paradigm of holistic scientific research, which is based on the concept that everything in life and matter is made up of vibration and energy. Vibrational technologies deliver powerful healing with no adverse side effects and at a low cost. Reliable studies prove its efficiency. Much of the vibrational technologies already exist and are accepted by Holistic Practitioners.
New Humanity Foundation’s Research and Development facility is currently testing vibrational health technologies and studying the effects of increasing their capacity for raising the Levels of Consciousness. With the aim to improve the existing technologies and innovate the new ones.
Why Technology?
Human consciousness is rapidly evolving, and so is technology. Many technological devices have been invented over the past 30 years for healing and general well-being. Many of these technologies have been medically and scientifically validated to support physical, mental health and emotional well-being.
​
Raising consciousness is the foundation of future development of humanity. Given the connection between emotional, mental and physical health on the one hand, and self-awareness and consciousness on the other hand, there is a need to explore the effects of these technologies on development of human consciousness.
Hyperbaric Oxygen Therapy (HBOT)
Deep Cellular Renewal & Longevity​

HBOT involves breathing pure oxygen in a pressurized chamber, allowing oxygen to dissolve deeply into tissues, blood plasma, and even bone - accelerating healing and rejuvenation at the cellular level. The therapy supports both physical recovery and mental clarity, making it a powerful tool for longevity, performance, and inner balance.
Key Benefits of HBOT:
​
-
Accelerated wound and tissue healing
Boosts cellular repair and tissue regeneration — healing 30–40% faster after injuries, surgeries, or physical strain. -
Reduces inflammation and oxidative stress
Neutralizes free radicals and lowers chronic inflammation, helping manage pain, autoimmune conditions, and aging processes. -
Enhances cognitive clarity and memory
Increases brain oxygenation, improving focus, memory (15–20%), and mental sharpness - especially helpful for brain fog or post-concussion recovery. -
Stimulates stem cell production
Promotes up to 8x more mesenchymal stem cells (MSCs), which play a crucial role in repair, immune regulation, and tissue renewal. -
Telomere lengthening & anti-aging effects
Clinical studies show telomere length can increase by up to 38%, while reducing senescent (aging) cells by over 30% — key markers of biological youth. -
Improves sleep, mood & emotional resilience
Balances nervous system activity, helping to regulate mood, reduce anxiety, and promote restorative sleep cycles. -
Supports heart, skin & metabolic health
Encourages angiogenesis (25% increased capillary density), improves insulin sensitivity, and enhances circulation — supporting long-term vitality. -
Fosters clarity & presence
By reducing internal "noise" from pain, fatigue, or inflammation, HBOT allows space for inner stillness, self-awareness, and non-dual practices.
Cryochamber

The Cryochamber uses ultra-cold air to trigger powerful healing responses in the body - all in just 2-3 minutes per session. By stimulating circulation, calming inflammation, and enhancing energy flow, cryotherapy supports both physical and mental clarity, making it an ideal tool for recovery, anti-aging, and present-moment awareness.
Key Benefits of Cryotherapy:
​
-
Reduces inflammation & pain
Eases joint pain, muscle soreness, and chronic inflammation — supporting mobility, comfort, and faster healing. -
Improves mood, focus & stress response
Boosts endorphins and regulates cortisol, helping to lift mood, sharpen concentration, and reduce anxiety. -
Enhances sleep & recovery
Supports deeper, more restful sleep and quicker post-exertion recovery by balancing the nervous system. -
Boosts circulation & metabolic health
Stimulates blood flow and activates brown fat, increasing energy use and improving insulin sensitivity. -
Supports cellular repair & anti-aging
Cold exposure encourages collagen production, activates longevity proteins (like SIRT1), and enhances skin tone. -
Fosters presence & mental stillness
By clearing physical discomfort and emotional fog, the Cryochamber creates space for mindful presence and spiritual grounding.
Red Light Therapy Devices
Red Light Therapy (RLT) uses safe, low-level red and near-infrared light to boost your body’s natural healing processes. Backed by science, RLT supports skin repair, reduces pain and inflammation, speeds up muscle recovery, improves circulation, helps your brain function better, eases stress, and enhances sleep. It's also becoming popular in anti-aging, trauma recovery, and spiritual wellness routines.

Between 2023 and 2025, RLT technology has advanced rapidly—devices are now more portable, affordable, and often include AI features. Many people are combining RLT with therapies like cryotherapy and hyperbaric oxygen (HBOT) for even greater results.
​
On a deeper level, Red Light Therapy helps clear the mind and body of distractions - like physical pain, stress, and mental noise - so you can feel more grounded, peaceful, and present in the NOW. This supports spiritual growth, meditation, and non-dual awareness.
​
Key Benefits:
​
-
Healthier Skin – Increases collagen by 15–20%, reducing wrinkles and improving tone.
-
Less Pain & Inflammation – Eases joint or muscle pain by up to 30%.
-
Faster Muscle Recovery – Reduces post-workout soreness by 25%.
-
Sharper Focus & Mood – Boosts memory, lowers stress, improves sleep by 15–20%.
-
Better Circulation & Metabolism – Supports heart health, insulin sensitivity, and energy.
-
Deeper Presence – Reduces stress and mental chatter, helping you feel grounded and connected.
What is hydrogen water?

Hydrogen water is water in which a higher content of molecular hydrogen is present. Molecular hydrogen (H2) is the world's smallest molecule.
​
The H2 molecules can get into our cells in a way that ordinary water can only dream of.​ And once there, they provide more energy to the cells and reduce oxidative stress, which is a culprit behind aging and disease.
​
The therapy is medically recognized in Japan and has over 1500+ scientific studies behind it.
​
Studies have shown that hydrogen has effects on almost all organs and over 31 disease categories, especially those affected by oxidative stress and inflammation.
​
Read more: www.nordhydrogen.com

Ananda Wellness
These amazing devices use 5 different energies delivered by what is known a Low Level PEMF therapy (Used by NASA for astronauts). PEMF is Pulsed Electro Magnetic Fields at a low level which are known to influence cell behaviour by inducing tiny electrical changes around and within the body’s cells.
​
-
Boost the activity of the mitochondria in the cells of the brain and body so that they perform better.
-
PEMF low level pulsed magnetic fields excite the brain’s neurons which allows them to dispense their own natural. chemicals like organic Dopamine helping to balance out deficiencies and restore normal brain functions.
-
Reduces stress, anxiety, and depression.
-
Provides pain relief.
-
Gives more energy naturally.
-
Reduces inflammation.
-
Increases bone density.
-
Enhances sleep.

Ananda Harmony
Bio-Photon Healing Equipments Six Elements of Healing in One Device
Contact: Chris Little ‪+356 7922 3481‬
Email: unlimitedananda@gmail.com
Location: St.Pauls Bay, Malta​

ARK Crystal Biotechnology

ARK Crystal biotechnology represents an innovative approach to enhancing biological systems using precisely engineered quartz crystals. This article will explore the design, manufacturing, mechanisms of action, and documented effects of ARK Crystals.
ARK Crystals are synthetically grown, high-purity quartz crystals cut into a specific tetrahedral geometry. The name “ARK” stands for Advanced Resonance Kinetics, reflecting the theoretical basis for their function.​
​
Read more here.

Devita BRT
This BRT device completely reverses and eliminates disorganized frequencies produced by the body, which is usually immediately perceived by the user and leads to the restriction and elimination (after continued use) of the organism's inflammatory processes. The device's service is so simple that anyone can use it, and no special knowledge is required for it. Just at the touch of a button!
DeVita BRT is entirely safe because it works only with human electromagnetic oscillations. Using the principle of inversion, the device promotes self-destruction of pathological changes.​
​
​Some characteristics of Devita BRT device:
-
An endogenous bio-resonance correction device.
-
It works only with the patient's own electromagnetic oscillations without using any external energy.
-
The device receives, amplifies and also inverts and returns to the individual its own electromagnetic oscillations.
-
In this case, the correction process happens directly under the influence of the "here and now".
-
With inversion, pathological oscillations are destroyed.
-
The effect promotes the elimination of endo- and exotoxins accumulated in the body.
-
The normal electromagnetic oscillations of an individual in the body repair process are not suppressed.
-
As a result of the correction, the defense forces of the organization become more active.
-
The most effective complex correction in the joint application of endogenous and exogenous organs.

NeoRhythm
Breakthrough in brain science
Sleep better, de-stress and boost energy with this next generation gesture-controlled headband.
​
Neo Rhythm features five inverted coils, strategically placed across the comfortable headband, to produce harmless electromagnetic fields that emit waves in patterns that your mind seeks to imitate.
Encourages our brain to mimic external signals provided by a device.
Our brains take a cue from the movement of the train and mirror the rhythm. The result is that your state of mind shifts into a preferred one.
​
-
The first of its kind neurostimulation band for mental and physical wellbeing.
-
Different program modes to help you meditate, de-stress, manage pain and more.
-
Designed by leading researchers in the field of electromagnetic therapy.
-
Scientifically validated technology based on years of research.
-
Trusted by doctors, researched and individuals across the world.
-
More than 7200 satisficed backers from all over the world.
-
Totally wireless and gestured-controlled. Ready to use in minutes.
-
Sleep and relaxation.
-
Meditation practice.
-
Mental performance.
-
Pain management.

OMI Pads
Bathes the entire body, and all its internal systems, in a pulsed electromagnetic field, using a complex “sawtooth” signal. The mat’s area is further modulated by a cycle of natural earth-based frequencies (determined by the time of day), including the Schumann Resonance. Using an additional layer of carbon-fiber mesh, the Hybrid mat is the first of its kind to combine a pure PEMF signal (used as a carrier for a spread of frequencies).​​
-
Promotes regeneration process at the cellular level (regenerating nerve fibers in the spinal cord and peripheral nerves, restoring, renewing).
-
Helps to maximize mental clarity, focus and productivity.
-
Works to the level of a cell that has lost charge and, due to the high intensity of the pulse, introducing a low-level electromagnetic field into the body can bring those charges back up and restore healthy electrochemical exchanges.
-
Opening pathways in the cell membranes. Speeds up the healing process and promotes energy flow.
-
Improving neurological functions and oxygenation.
-
Re-energising and opening pathways in the cell membranes.

Muse
Muse is a powerful, compact electroencephalography (EEG) system. Our industry leading dry electrode technology and ultra-portable design, Muse makes it easy to access and use brainwave data, inside and outside the laboratory and in real-world environments.
​
-
Increases awareness of mind-body connection; powerful, accurate real-time feedback on brain activity, heart rate, breathing, and body movements.
-
Increased grey matter density, reduced thinning of the prefrontal cortex, decreasing amygdala activity (associated with stress response), and increased resilience – basically, an overall beneficial change of the brain’s structure and function.
-
A significantly large reduction in stress – a 16% reduction in perceived stress in just four weeks.
-
Focus + Mental Performance: improvement in mental performance and reaction times compared to controls.
-
Relaxation: changes resting brain states; (similar to the changes seen in the brains of mindfulness meditators); improved control of participants’ ability to relax.

Denas PCM
DENAS-PСM is a dynamic electro neurostimulation device - an excellent tool with a choice of different frequencies.
Depending on the selected frequency, you can get different therapeutic effects. Some frequencies are in demand for the treatment of pain syndromes, others - for normalization of pressure, the third - to relieve inflammation, etc.​
​
In addition, the models are equipped with special preventive programs, and many modes to assess the effectiveness of treatment and identify problem areas.
The lead is a conductor that carries electrical currents to the electrode, which interfaces directly with the excitable tissue.​​
​
-
Signals directly to the nervous system.
-
Activates or inhibits excitable tissue, such as the nervous system or heart, through the delivery of electrical currents through electrodes.
-
Cardiac stimulation.
-
Depolarization or hyperpolarization of the nerve cells.
-
Therapeutic alteration of activity in the central, peripheral, or autonomic nervous systems.
-
Discharges electrical current.
-
Alleviating symptoms of movement disorders.
-
Membrane depolarization; activating voltage-sensitive ion channels responsible for action potential generation.
-
Correction of psycho-emotional state and for prolonged effect of pain relief, organ restoration and brain frequency.

Quantum Magnetic Resonance Analyser
In cell division and renewal, bodies are loaded by extranuclear electrons that migrate continuously at high speed by emitting electromagnetic waves without interruption. These emitted electromagnetic signals by the human body are the signature, whether it is healthy or unhealthy. A Quantum analyzer is a new instrument to analyze this phenomenon.
Merely taking a sensor in the palm of your hand, data on the body's various health systems are collected in a few minutes. ​
-
This method is a fast, accurate and non-invasive diagnosis. The main elements of analysis are: cardiovascular and cerebrovascular disease, bone mineral density, trace elements, heavy metals, rheumatism, lungs and respiratory tract, kidney, blood glucose, the stomach, intestines, liver, gallbladder, cranial nerves, gynecological, prostate, bone diseases, trace elements (selenium, iron, zinc, calcium, etc.).
-
Measures the response of a subject to be tested, and compared with the reference material, it allows to recognize the deviation from the desired response.
-
Predicts the precursor of disease and effectively prevent the various chronic diseases
-
The analysis will tell you the condition of your health without ultrasound, nuclear magnetic resonance, X-ray or other invasive test.
-
It is simple in operation, easy interpretation, without the need of health checks, and it can be done anywhere and at any time.

Sensate
Sensate is a revolutionary way to tone your vagus nerve and tap into all of the health benefits that people typically experience as a result.
Sensate synchronizes infrasound vibrations with hemispheric audio to provide a full-body sensory experience that lowers stress, reduces anxiety, improves focus, and augments mental resilience.
The foundation of the Sensate experience is a collection of musical soundscapes. The resonating hum of the device works on the vagus nerve through the science of bone conduction.
-
Eliminates/soothenes fight or flight response. Calms down nervous system​​.
-
Release of tension without distraction of the mind.
-
Changes body’s responses to stressful situations, both internal and external. Allowing effectively to respond to the emotional and physiological symptoms.
-
Reducing the negative effects of physical, emotional, and psychological wear-and-tear on the bodies.
-
Strengthens immune system and digestive (works through vagus nerve).
-
Stimulates natural response to balance.
-
Supports natural body/mind healing.

Chi Generator JU1000
A productive and clean life force generates a feeling of well-being and harmony, as we feel in nature. It is undoubtedly, an excellent way to protect your family from the Electrosmog because it reduces the impact of electromagnetic pollution on the body and strengthens the cells with vital force.
​
-
Life force eliminates the mental imbalance. Calms the mind. Boosts memory.
-
Improves extra sensory projection
-
Strengthens the cells with vital force. Enhances natural aliveness.
-
Heightened awareness of surroundings, better concentration, focus.
-
Induces relaxation and creativity.
-
Vital life energy helps to reduce emotional and physical symptoms
-
Helps to align with one’s natural life force. Enhances inspiration.

Violet Ray
The violet ray is a high frequency, low amperage source of static electricity. This high-voltage device is based upon a disruptive discharge coil design invented by Nikola Tesla. Treatment with any surface attachment that smooths the skin will eliminate wrinkles and ozone will rejuvenate the skin.
​
Electrotherapy is primarily used in physical therapy for relaxation of muscle spasms, prevention and retardation of disuse atrophy,
increase of local blood circulation, muscle rehabilitation and re-education electrical muscle stimulation, maintaining and increasing range of motion, management of chronic and intractable pain, post-traumatic acute pain, post-surgical acute pain, immediate post-surgical stimulation of muscles to prevent venous thrombosis, wound healing and drug delivery.
-
Encourages cellular turnover and improves product penetration.
-
A stimulus to blood circulation and also to nerve action.
-
Reduces congestion and inflammation affecting every system in the body.
-
Inducing relaxation in cardiac and nerves. Improves heart function.
-
Healing skin lesions and infections. Works as antiseptic.
-
Increases the elimination of nitrogenous products and toxicity.
-
Assists in restoring normal function to the lymphatic system.
-
Increase oxidization and glandular activity.
-
Soothing to the nervous system.
Grounding
Grounding, or earthing, refers to connecting electrically with the Earth. A growing body of research is finding numerous health benefits as a result of the physical body being grounded.
​
Unfortunately, with our modern rubber or plastic soled shoes and insulated sleeping arrangements, we no longer have a natural electrical connection to the Earth, unless walking barefoot.
The effect of grounding on the blood
One of the most dramatic demonstrations of the benefits of grounding is the effect it has on the blood.
​
On the right are darkfield microscope images of blood taken from three individuals just before and after forty minutes of grounding.
​
The before images are on the left, the after on the right. The pictures clearly show a dramatic thinning and decoupling of the blood cells.
​
The blood samples were taken during research into grounding by Dr Stephen Sinatra MD.

Groundology offers a range of grounding (earthing) products designed to help people reconnect with the Earth's natural energy.
Their products aim to reduce exposure to electromagnetic fields (EMFs), improve sleep, and support overall well-being.​​
​
Learn More: www.groundology.co.uk
​The range includes:
-
Bedding and sheets that allow you to stay grounded while sleeping.
-
Mats and patches for grounding at home, at work, or on the go.
-
Footwear and accessories to make grounding possible while walking or standing.
-
Tools and extras like cords, plugs, and testers to set up a safe grounding system.
-
Personal Grounding Kits: A portable solution featuring a grounding band, coiled cord, and Earth connection plug, suitable for use indoors or during sleep.

Atlantic Clinic
https://atlantis-group.org/clinic
​
​Contact: Mark Christian
WhatsApp: +356 7942 9302
Disclaimer
I understand that New Humanity Divine Marga teachers do not diagnose conditions nor do they prescribe or perform medical treatment, prescribe substances or interfere with the treatment of a licensed medical or psychiatric professional.
